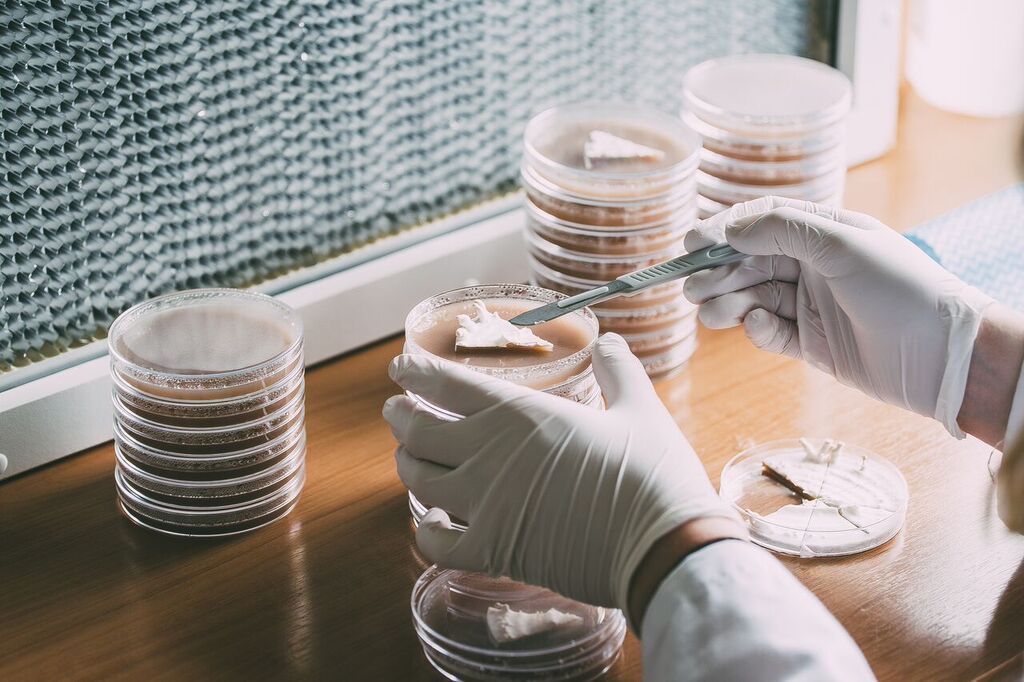

Want to start a mushroom growing business, but worried that you need a crazy amount of infrastructure, time and money? Don’t worry. You can be up and growing with a simple, cost-effective system and a bit of ingenuity. Here’s how.
1. Get skilled up.
First up, you need to skill up. Milkwood Permaculture’s Gourmet Mushroom Cultivation Course is an excellent place to start if you’re on the continent. If you’re in Tasmania, check out Forest Fungi’s courses. Put it on your Christmas or birthday wish list (estimated cost: free).
2. Set up your laboratory
Now you have the skills, you need to set up your lab. It doesn’t need to be in a purpose-built building. You can start a lab in a spare room, shed or caravan. You’ll need power, but that’s nothing an outdoor extension cord can’t fix. My laboratory is housed in a salvaged caravan annex, and it works great.
Kit it out with a big desk/table – cruise through your neighbourhood for something suitable curbside or hit up your local tip buy-back (estimated cost $50). I bought mine for $5 at a government buy-back in Canberra and it’s near indestructible.
Next you’ll need shelving, preferably metal. Wooden shelving isn’t great as it can get mouldy quickly (trust me, it sucks – stick to something you can keep clean). Most hardware stores stock a basic three or four-level metal shelving unit ($14 each); you just need to put them together (it’s like Meccano for adults!). Start with two or three shelving units and add more as you expand (total upfront shelving cost: $42).
Your indispensable pieces of kit (and your biggest investments) are:
- A High Efficiency Particulate Air (HEPA) filter – lurk around on eBay and Gumtree for a medium-sized unit (estimated cost: $300).
- A pressure cooker – The All American 921 is the perfect all-rounder (estimated cost: $350 including shipping from the USA).
Now your lab is really looking like a lab! Get your lab consumables – you’ll need sterile petri dishes ($19.80 for 100), scalpels ($4.90 for 10), nitrile gloves ($12.65 for 100) and parafilm ($39.50 for 76m). There are a bunch of great scientific suppliers online (I use Wiltronics and Anpros, but they are just two of many). Also, I recommend buying a dedicated hotplate for your pressure cooker ($70). I fractured a cooktop with my pressure cooker and had to shell out for a replacement – not ideal. Google ‘pressure cooker fails’ if you’re still on the fence. Yikes.
For your agar nutrient media, you’ll need agar agar ($35.50 for 200g from Melbourne Food Depot), malted milo ($5 at your local supermarket; if you can’t find malted milo, you can use a combination of regular milo and malted milk powder), hydrogen peroxide ($4.50 for 200 mL at your local pharmacy) and some premium dog dry food ($14.50 for a medium bag). Collect some 700mL passata bottles from your weekly pasta night and you’re good to go.
For grain spawn, you’ll need grain and growing containers. You can generally find good quality wheat or rye at rural country stores or similar ($20 for 25 kg). You can easily source plastic containers online, just make sure you re-use them as long as possible ($46 for 500 x 900 mL containers from WF Plastic), or you can look around for secondhand glass mason jars at your local op-shop. Make sure they fit in your pressure cooker!
To round it out, you’ll need some cloth wipes ($8 for a roll of 100), a spray bottle ($3) and some methylated spirits ($15) to wipe down your work surface.
3. Organise a Grow room
So your lab is pumping, and you have petri dish cultures and grain spawn lining your shelves. Excellent. Now you need somewhere to grow your mushrooms. Start simple – if you have a shady spot in the garden you can cover with shade cloth, do that! Do you have a garden shed that’s not being used? Excellent news, my friend. My first grow room was a dark polytunnel made from star pickets, poly pipe, black plastic and an old trampoline cover ($150 total).
You’ll need growing containers. Mushroom bags (type 14A, Unicorn Bags, USA) are pricey, and you have to buy in bulk. Start with the bucket-in-a-bucket method and pick up some secondhand 20 L buckets from local nurseries or new ones from your local hardware store ($12 each, say ten buckets for a total of $120). Get inventive – animal feed bags, hessian sacks and plastic pots can also be used to grow mushrooms. You can build up to using professional mushroom bags, or split the cost of the minimum order of 1000 with some mushroom growing friends.
Substrate-wise, look for what’s cheap and local. What cereals are being grown in your area? Oyster mushrooms in particular love growing on cereal straw. If you can’t access local cereals, sugarcane mulch is a great alternative ($14 per bale). If you’re growing a hardwood-loving mushroom, get in touch with your local arborist or landscaper – they’ll have a tonne of processed hardwood and sawdust you can use (you can always barter with your soon-to-be-grown-shrooms or a case of beer). In addition to substrate, you’ll need hydrated lime ($18 from your local country store or similar).
You’ll also need a large mixing container and draining sacks to prepare your substrate. Pick up a secondhand bathtub or large plastic container at your local tip buy-back ($10) and source some large hessian sacks from a bulk pet or rural country store ($8, say two sacks for a total of $16).
4. Create a website and advertise
Decide on a name for your business and buy your web domain (make sure it’s simple and no one already has it; $17 per year). Set up a simple website using Squarespace, Weebly or any other simple design platform. A basic site is free (you can always upgrade later on, the important thing is to create a landing page so people can read about your business). Create a dedicated email address for your business and start an Instagram account – both of these make it easy to network with local restaurants and farmers markets (and both are free).
Create a simple logo or find someone to draw/design one for you, and create a basic business card ($10 for 250 business cards, Vistaprint). There’s probably something you’re good at that you can trade for artistic services – can you do taxes really well, or do you make killer triple citrus marmalade? Work your angles.
Drop into your fave local cafes and restaurants with a sample of your mushrooms and your kick-ass business card (before service starts; no chef will want to talk about your produce if they’re juggling six hot pans). Contact your local farmers market to see if you can snag a spot. Of course they want you! You freaking grow mushrooms!
TOTAL COST: $1395.35
Congrats! You’re officially a mushroom grower, and you did it without breaking the bank.